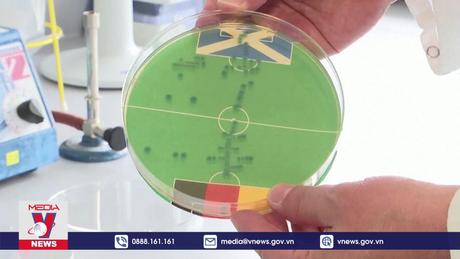
Dự đoán kết quả EURO 2024 bằng vi khuẩn E. COLI

Nước Đức sẵn sàng cho một mùa Euro sôi động
14-06-2024, 18:23
Đây là sự kiện được mong chờ nhất trong năm của châu Âu cũng như thế giới, với sự góp mặt của những đội bóng và ngôi sao hàng đầu, hứa hẹn mang đến những trận đấu hấp dẫn, kịch tính. Càng đến gần giờ G bầu không khí càng nóng, an ninh tại nước chủ nhà Đức cũng được siết chặt.
tin mới
Iran công bố dự thảo biên bản ghi nhớ với Mỹ
28-05-2026, 06:00
Tây Ninh: Hành trình đưa đồng đội trở về đất mẹ
28-05-2026, 06:00
Khả năng Mỹ cắt giảm khí tài quân sự cho NATO
28-05-2026, 06:00
WHO kêu gọi chấm dứt xung đột ở CHDC Congo để kiểm soát dịch Ebola
28-05-2026, 06:00
Thanh Hóa: Căng mình "canh lửa" giữ rừng mùa nắng nóng
28-05-2026, 06:00